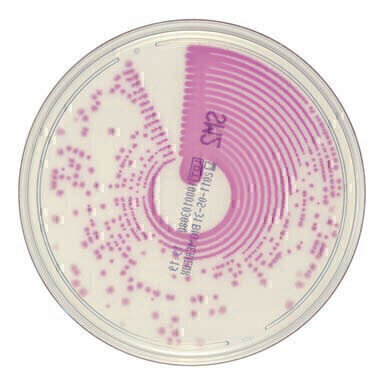
Chromogenic Media Detects S. typhi and S. paratyphi

Laboratory products
Chromogenic Media Detects S. typhi and S. paratyphi
Jan 26 2012
bioMérieux’s chromID Salmonella takes advantage of three chromogenic substrates to selectively isolate and differentiate all Salmonella serotypes, including S. typhi and S. paratyphi.
Salmonella spp. are observed 18 – 24 hours after incubation as pale pink to mauve colonies on a colourless background and are easily distinguished from non-Salmonella spp. which appear as blue, turquoise or colourless colonies. This optimum differentiation of cultures virtually eliminates the risk of missing a Salmonella infection.
The performance of chromID Salmonella is enhanced by the medium’s increased nutrient capacity and colour intensity, while the specific esterase activity from Salmonella increases the sensitivity of detection and specificity of colouration, offering greater reliability and performance than previously achievable. Identification and susceptibility testing of Salmonella isolated on this chromID medium correlates well with tests performed after isolation on
a reference medium1, avoiding the need for subculture of strains. Microbiologists using chromID Salmonella can take advantage of a complete solution for the detection of Salmonella, simultaneously benefitting from considerable savings in time and money.
Digital Edition
Lab Asia Dec 2025
December 2025
Chromatography Articles- Cutting-edge sample preparation tools help laboratories to stay ahead of the curveMass Spectrometry & Spectroscopy Articles- Unlocking the complexity of metabolomics: Pushi...
View all digital editions
Events
Jan 21 2026 Tokyo, Japan
Jan 28 2026 Tokyo, Japan
Jan 29 2026 New Delhi, India
Feb 07 2026 Boston, MA, USA
Asia Pharma Expo/Asia Lab Expo
Feb 12 2026 Dhaka, Bangladesh